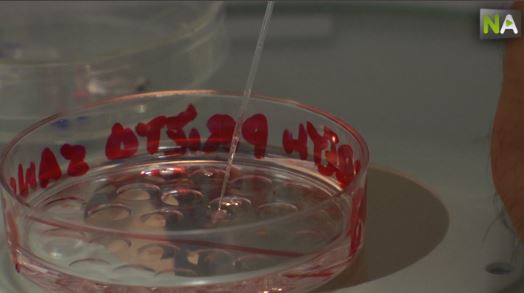
Befruchtung

Eine neue Technik verhindert, dass Embryonen in direkten Kontakt mit dem flüssigen Stickstoff kommen, der zum Einfrieren verwendet wird. Auf diese Weise kann das Risiko einer Verunreinigung vermieden werden. Darüber hinaus wird das Einfrieren und Auftauen beschleunigt und die Überlebensrate der Embryonen, des Spermas und der Eizellen steigt mit der Kryotechnik auf bis zu 100%.




